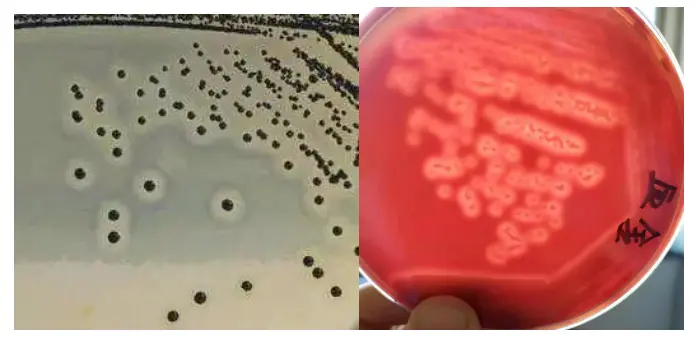
金黄色葡萄球菌培养特征

分辨金黄色葡萄球菌,你值得拥有
发布时间:2023-02-17 浏览次数:6189
一、什么是金黄色葡萄球菌?
金黄色葡萄球菌是一种常见的食源性致病微生物,其繁殖过程中产生的肠毒素是引发食物中毒的致病因子。该菌最适宜生长温度为37℃,pH为7.4,耐高盐,可在盐浓度接近10%的环境中生长。金黄色葡萄球菌常寄生于人和动物的皮肤、鼻腔、咽喉、肠胃、痈、化脓疮口;空气、污水等环境中也无处不在。

二、金黄色葡萄球菌的危害?
金黄色葡萄球菌本身不会对人体健康产生危害,但其繁殖过程中产生的肠毒素是主要的致病因子。金黄色葡萄球菌产生的肠毒素具有极强的耐热性,在100℃加热条件下仍能存活30分钟不失去其活性,可存在于已经煮熟的食物中,导致食物中毒。
食用金黄色葡萄球菌污染的食物是否会对人体产生危害,主要取决于污染食物中肠毒素的残留量。肠毒素对人体的中毒剂量存在明显的人群差异,一般认为是20~25μg。一般情况下,人体摄入带有达到致病量肠毒素的食物2~6小时后,出现恶心、呕吐和腹泻、腹痛、绞痛等急性胃肠炎症状,无发热,没有传染性,中毒症状通常会持续1~2天,轻度患者可以自愈,较严重者经治疗后可以较快恢复,愈后一般良好。但儿童对肠毒素比成人敏感,发病率高、病情重,需特别关注。
三、金黄色葡萄球菌感染的传播途径
一般来说,金黄色葡萄球菌可通过以下途径污染食品:食品加工人员、炊事员或销售人员带菌,造成食品污染;食品在加工前本身带菌,或在加工过程中受到了污染,产生了肠毒素,引起食物中毒;熟食制品包装不严,运输过程受到污染;奶牛患化脓性乳腺炎或禽畜局部化脓时,对肉体其他部位的污染。
四、培养特征
金黄色葡萄球菌营养要求不高,在普通培养基上生长良好,需氧或兼性厌氧,最适生长温度37℃,最适生长pH 7.4。
常见金黄色葡萄球菌在BP上的可疑菌落呈圆形,较小(2-3 mm),凸起,颜色呈灰黑色至黑色(黑色居多),最主要的现象是菌落周围有透明环出现(该平板在含有氮源的基础上,补充了促进细菌生长的丙酮酸钠,又含有抑制剂:亚碲酸钾,故有较好的选择性。但对于金葡萄球菌没有抑制,其能将亚碲酸钾还原为碲在菌落中心呈黑色,易于观察;加入卵黄,由于卵磷酯酶阳性特征,其菌落周围可出现一明显的沉淀环);在血平板上菌落较大,圆形,光滑凸起,菌落周围可以看见完全透明溶血圈。结合两种培养基特性确定可以菌落。
五、关于金黄色葡萄球菌在BP平板上的形态以及后续生化分析
第一种形态:

第二种形态:

第三种形态:

第四种形态:

一些典型可疑平板图如下:

六、血浆凝固酶试验
挑取Baird-Parker平板或血平板上至少5个可疑菌落(小于5个全选),分别接 种到5mLBHI和营养琼脂小斜面,36 ℃±1 ℃培养18h~24h。
购买冻干兔血浆,按照说明加入0.5mL生理盐水复溶。再加入0.3mLBHI培养物,混匀,置于恒温恒湿培养箱中培养,每半小时观察一次凝集情况,连续观察6 h(根据经验,若强阳性,一般在1-2 h就会凝集了,还遇到半个小时凝集的,长的在3 h左右凝集。注意:切忌一直放那里不观察,直接放6 h去看,因为凝固后,还会发生自溶现象的,隔夜自溶是常见的。)判断凝集的最好方法就是倒立,观察结块,效果最好的就是倒立后内容物不下落。


关于金黄色葡萄糖检验解决方案内容文章链接:/show/7917.html
作者:暴躁的小恐龙、食品小测
文字来源:网络资料、食品论坛网友分享,
图片来源:图片,网友分享,封面图来源创可贴会员,食品微生物检测小编汇编整理。
说明:转载只为分享目的,如有侵权请联系删除,谢谢!











